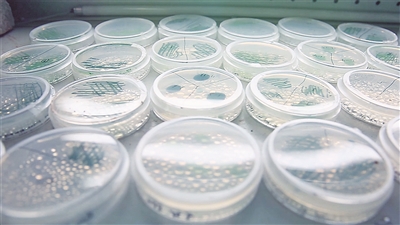

□青岛日报/观海新闻记者 丁倩倩
近日,青岛中科蓝智生物科技发展有限公司(简称“中科蓝智”)与儿童护肤热销品牌海龟爸爸达成合作协议,中科蓝智从天然螺旋藻中提取的甘油葡糖苷由此进入儿童个护领域,拓宽了产品应用的细分市场。
中科蓝智的好消息不只一个。不久前,中科蓝智刚刚完成A+轮融资,正式与海棠基金、尚势资本、天津洋开等投资机构签约,融资金额数千万元,公司估值达2亿元。
中科蓝智成立于2018年,由中科院青岛生物能源与过程研究所(简称“青岛能源所”)孵化,创始团队由该所微生物制造工程中心的多名科研人员共同组成,主营产品是通过生物合成技术获得的甘油葡糖苷。
从功效护肤到卫生大健康
甘油葡糖苷是糖苷类化合物,于人体而言具有补水保湿、修复、抗衰、舒缓等作用,在化妆品、食品、医药等领域具有极大应用潜力。
传统上,甘油葡糖苷通过化学合成或生物酶催化法获得,但上述方法容易产生杂质,提纯难度大。青岛能源所通过多年研究发现,甘油葡糖苷可于螺旋藻细胞内合成,并实现甘油葡糖苷规模化培养、提取、分离、纯化等。依托中科蓝智,甘油葡糖苷以“安诺因”的品牌命名走向市场。
“安诺因产品纯度高达99%以上,居于行业领先地位,安全性和功效更突出。”中科蓝智董事长段仰凯介绍,“安诺因”现已实现规模化稳定量产,产品应用最先在功效护肤品领域破局,并迅速获得一批行业订单,目前已应用于珀莱雅、逐本等品牌的舒缓抗衰类产品。
功效护肤品产业规模近年来增长迅速,艾瑞咨询研究报告显示,2020年中国功效型护肤品行业规模已达到260.1亿元,并将以29.4%的年均复合增速继续增长,于2023年达到589.7亿元。
但同时段仰凯表示,化妆品原料的门槛低,且激烈的价格竞争挤压了原料的利润空间,为此中科蓝智不断拓宽产品应用领域。目前,中科蓝智已从功效护肤扩大到健康护理领域,与云南白药、马应龙、海氏海诺等品牌达成合作。另外,从2022年起,中科蓝智便着手为“安诺因”申请二类医疗器械注册——相较于“妆字号”,“械字号”的准入门槛更高,产品的市场和利润空间也就更好,“年内,安诺因的械字号有望审批下来,我们还在筹备向‘消字号’以及三类医疗器械等更高标准进阶,不断扩大安诺因应用的细分市场。”段仰凯说。
甘油葡糖苷之外,螺旋藻的“剩余价值”也不容小觑。据介绍,中科蓝智甘油葡糖苷提纯技术实现物理法无损提取,该方法确保了成分提取后螺旋藻细胞的完整性,这使得螺旋藻自身原有的经济价值不受影响,“为把培养的螺旋藻‘吃干榨净’,我们还研发出甘油葡糖苷—藻蓝蛋白—藻多肽等活性物联产技术,实现螺旋藻的高值化综合利用,整体经济价值再度提升,约为传统螺旋藻产值的60倍。”段仰凯表示。
从实验室到产业化
科技成果转化有多种途径,如向成熟的产业体系进行技术转让,或者以“作价入股”的方式加入企业,再或者自主创业。“我们当时也面临这样的抉择,放眼行业,尚不存在一个成熟的产业体系可以承接微藻合成甘油葡糖苷的规模化生产,所以我们最终选择了自主创业。”段仰凯说,2020年他从青岛能源所离岗,全职管理运营中科蓝智。
从研究员到企业家,段仰凯面临思维模式的转换,“研究人员的关注点都在产品技术指标上,但品牌方更关注用户体验。”段仰凯说,刚跑市场时经常碰壁,在不断碰壁中,中科蓝智的产品越来越符合市场需求。
随着产品一步步市场化,中科蓝智的团队也逐步搭建完善,“最开始,销售主要走代销渠道,随着市场慢慢打开,直销业务的比例占比提升,公司就分别组建了渠道管理和营销管理团队;原来的产品应用场景逐渐不能满足合作需求,就组建研发管理团队,专门研究拓宽产品的应用领域。”从最初段仰凯带着两个工人在莱西从事螺旋藻培养、生产甘油葡糖苷,到目前公司成员达到40人,中科蓝智的生产基地也从青岛扩展到了江苏。段仰凯说,“实际上中科蓝智推出的不只是甘油葡糖苷,更是将研究所相关技术成果在食药妆行业领域的产业化通路打通了。目前,中科蓝智已有了稳定的品牌合作方和投融资渠道,可以承接其他合成生物学领域的技术成果转化,这也将是公司未来业务的重要组成。”
截至目前,公司已布局46项专利,并获国家高新技术企业和青岛市“专精特新”中小企业认定。
从到处找资本到资本找上门
中科蓝智是在资本浸润下成长起来的企业。
2019年中科蓝智刚实现产品定型,需要资金租厂房、买设备。“当时创始人团队拿着一份PPT为中科蓝智争取了数百万元天使轮融资,靠这些资金,中科蓝智撑了一年半的时间。”段仰凯介绍。
2021年,中科蓝智完成甘油葡糖苷纯品工业化生产,正式进入商业化运营阶段,同时基于在产品功效上的挖掘,开拓出抗炎、修复等应用场景,在人宠大卫生健康等细分领域有了合作品牌,带着新的发展成果和资金需求,段仰凯试图寻找新的投资人。
在段仰凯看来,资本市场在科创企业成长中必不可少,但对接过程并不舒适,“投资人问我,中科蓝智的估值是多少?市盈率是多少?财务报表如何?问得我一头汗。”段仰凯说,当时他并不知道这些财务专业词汇,与投资人交谈完之后赶紧补课。虽然没能对答如流,这位投资人还是在A轮投了中科蓝智,“现在他是安诺因产品的忠实粉丝,每次新产品出来都积极试用。”段仰凯笑着说。
2022年,中科蓝智销售额实现翻倍增长,资本方开始火速下注,从A轮到A+轮,中科蓝智仅用了1年时间,比上一轮融资周期缩短半年。
这一年的时间段仰凯密集地接触了不少投资人,有意向的投资人明显要比之前多,“最终中科蓝智选择了由40位实业家共同组建的海棠基金,主要看重投资机构的赋能属性,能为中科蓝智带来更多产业资源。”段仰凯说,虽然目前暂时资本充足,但他还是会多见见投资人,“一方面为中科蓝智的发展提供专业建议,另一方面也是为企业下一步发展积蓄力量。”




 前一期
前一期